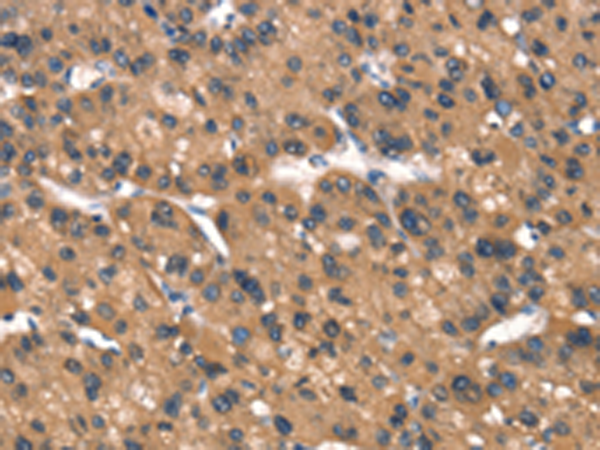

|
Background: |
Cell motility, adhesion, cytokinesis, and other functions of the cell cortex are mediated by reorganization of the actin cytoskeleton and several formin homology (FH) proteins have been associated with these processes. The protein encoded by this gene contains two FH domains and belongs to a novel FH protein subfamily implicated in cell polarity. A key regulator of cytoskeletal architecture, the small GTPase Rho, is activated during development by Wnt/Fz signaling to control cell polarity and movement. The protein encoded by this gene is thought to function as a scaffolding protein for the Wnt-induced assembly of a disheveled (Dvl)-Rho complex. |
|
Applications: |
ELISA, WB, IHC |
|
Name of antibody: |
DAAM1 |
|
Immunogen: |
Synthetic peptide of human DAAM1 |
|
Full name: |
dishevelled associated activator of morphogenesis 1 |
|
SwissProt: |
Q9Y4D1 |
|
ELISA Recommended dilution: |
1000-2000 |
|
IHC positive control: |
Human liver cancer and Human gastric cancer |
|
IHC Recommend dilution: |
50-200 |
|
WB Predicted band size: |
123 kDa |
|
WB Positive control: |
Hela and 293T cells |
|
WB Recommended dilution: |
200-1000 |
購物車
幫助
021-54845833/15800441009
